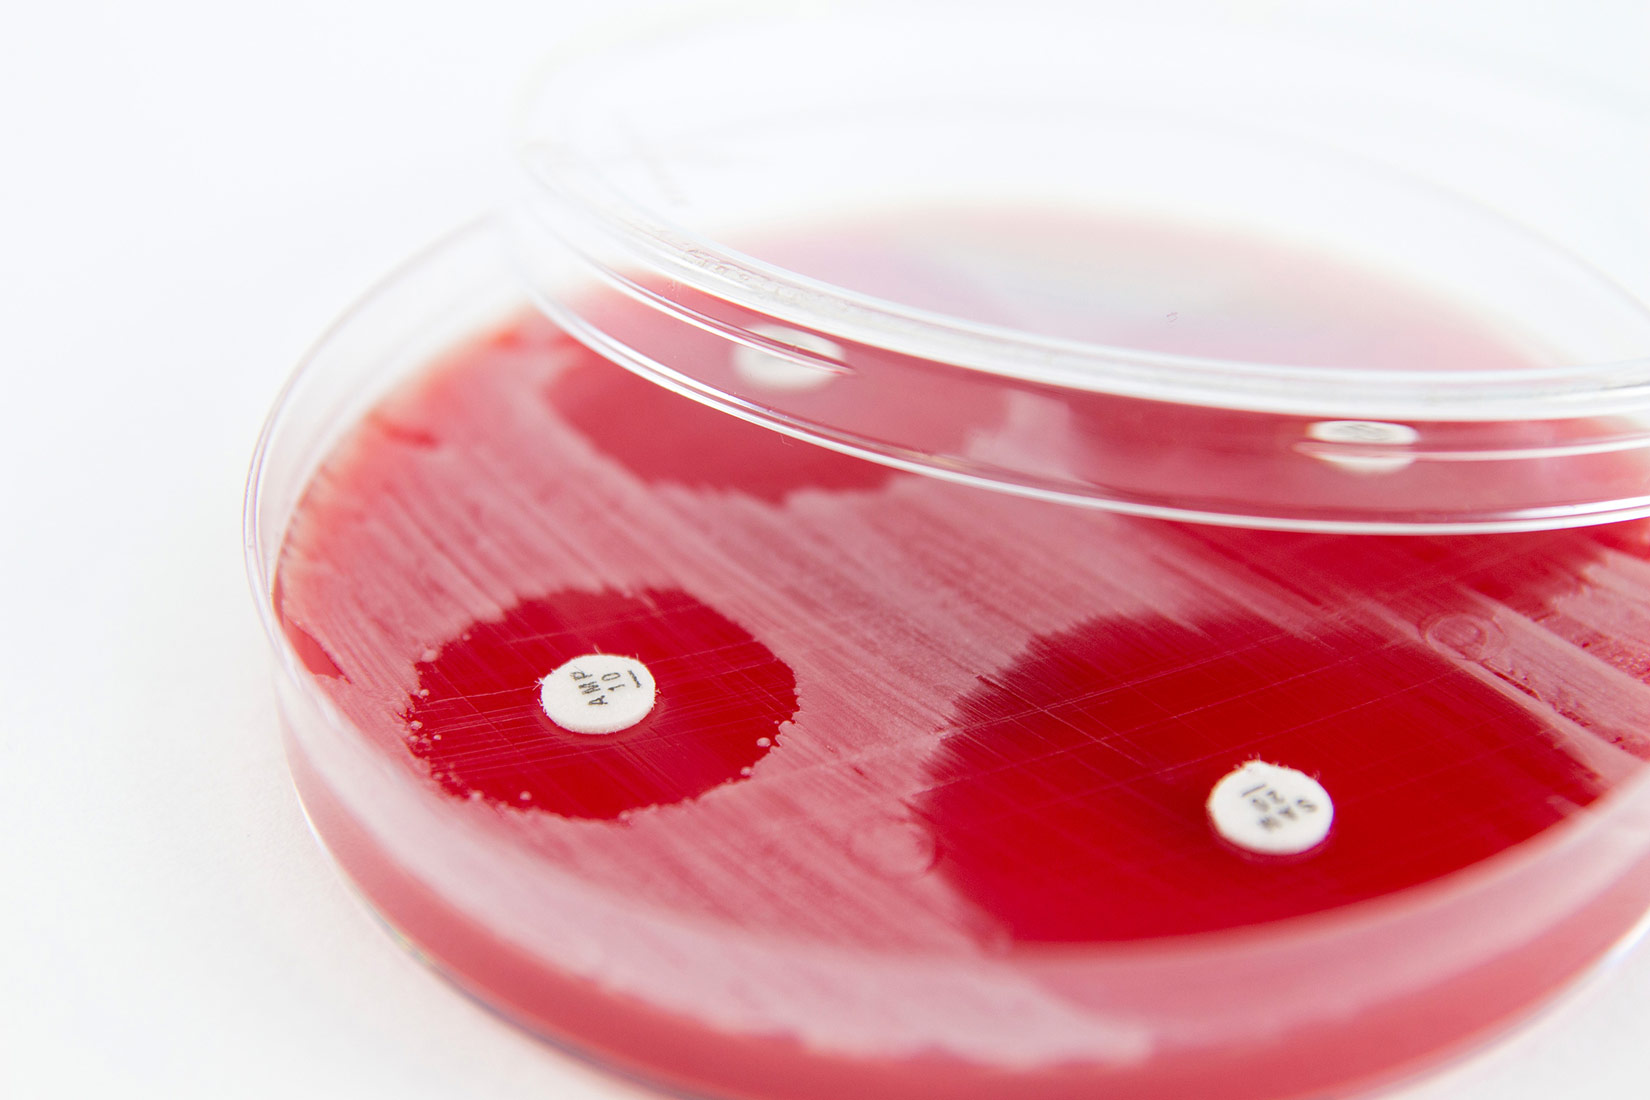
Slika 2. Slika prikazuje čestice antibiotika na hranjivoj podlozi

Virusi i prokariotski organizmi
2.1.Virusi
Krpelji su najčešći vektori u Hrvatskoj
Krpelji često prenose virus koji može uzrokovati meningitis, upalu zaštitnih ovojnica mozga koja pritom bubri i pritišće mozak. Krpelji prenose i bakterije uzročnike bolesti Lajmske borelioze koja je česta u sjeverozapadnim dijelovima Hrvatske.
Samo manji broj krpelja prenosi virusne i druge uzročnike bolesti, no svejedno je jako bitno pregledati tijelo nakon boravka u prirodi. Ukoliko pronađete krpelja, potrebno ga je pažljivo izvaditi iz kože.
Pincetom uhvatite krpelja što bliže njegovim ustima (dio tijela koji je pod kožom). Nikako ne pokušavajte uhvatiti krpelja za odebljali zadak jer možete istisnuti štetne tekućine u krvotok. Polagano izvucite krpelja iz kože bez izvrtanja pincete kako se glavopršnjak ne bi otkinuo i zaostao u tijelu.
Područje kože iz kojeg je izvučen krpelj temeljito isperite vodom. Ako ne možete sami izvaditi krpelja, uputite se svome liječniku! Nikako ne pokušavajte ubiti krpelja plamenom, alkoholom ili drugim kemijskim sredstvima dok je pričvršćen za kožu jer će ispustiti tekućinu, što može povećati opasnost od infekcije.
Creutzfeldt-Jakobova bolest („kravlje ludilo“)
Na fotografiji je prikazano živčano tkivo (ružičasto) zaraženo prionima. Bijele mrlje prikazuju područja uništena zarazom zbog kojih živčano tkivo poprima spužvast izgled.
Moždano tkivo zaraženo prionom postaje spužvasto i smanjuje se uzrokujući brojne komplikacije poput promjena u ponašanju, gubitka pamćenja i naposlijetku smrti. Lijeva fotografija prikazuje zdravi, a desna bolestan mozak.
Mozak je skeniran magnetskom rezonancom.
2.2.Bakterije
Fotoautotrofne bakterije
Cijanobakterije su najraširenije autotrofne bakterije na Zemlji, nalazimo ih u svim vodenim i kopnenim ekosustavima i kao simbionte u lišajevima.
Kolonije cijanobakterija promatrane mikroskopom
Purpurne bakterije za svoju fotosintezu ne trebaju vodu, već sumporovodik tako da ne stvaraju kisik. Koja tvar je produkt fotosinteze ovih bakterija umjesto kisika?
Kemoautotrofne bakterije
U kopnenim vodama na tlu bogatom željezovim spojevima žive željezne bakterije koje energiju dobivaju oksidacijom iona željeza. Voda u kojoj žive mora biti siromašna kisikom poput močvara, a često ih nalazimo i u zagađenim vodama. Zašto prisutnost kisika sprječava razvoj ovih bakterija?
Nitrifikacijske (dušične) bakterije nalazimo u svim tipovima tla, one energiju dobivaju pretvaranjem amonijevih iona iz tla u nitritne i nitratne ione. Imaju veliku ekološku važnost za biljne organizme.
Sumporne bakterije dobivaju energiju oksidiranjem sumpornih spojeva. Ove bakterije često žive u ekstremnim uvjetima poput termalnih izvora ili slanih jezera.
Gnojenje
Umjetno gnojivo sastoji se od anorganskih spojeva poput nitratnih soli natrija. Često korištenje anorganskih gnojiva može imati loš utjecaj na okoliš.
Kompostiranje je kontrolirana bakterijska razgradnja kuhinjskog otpada koji koristimo kao gnojivo. Organska gnojiva poput komposta sadrže manje minerala od anorganskih, ali ne oštećuju okoliš.
Zelena gnojidba je sadnja biljaka koje su u simbiozi s nitrofiksacijskim bakterijama. Tlo se takvom sadnjom obogaćuje dušikovim spojevima. Navedite nekoliko primjera biljaka koje se mogu koristiti za zelenu gnojidbu.